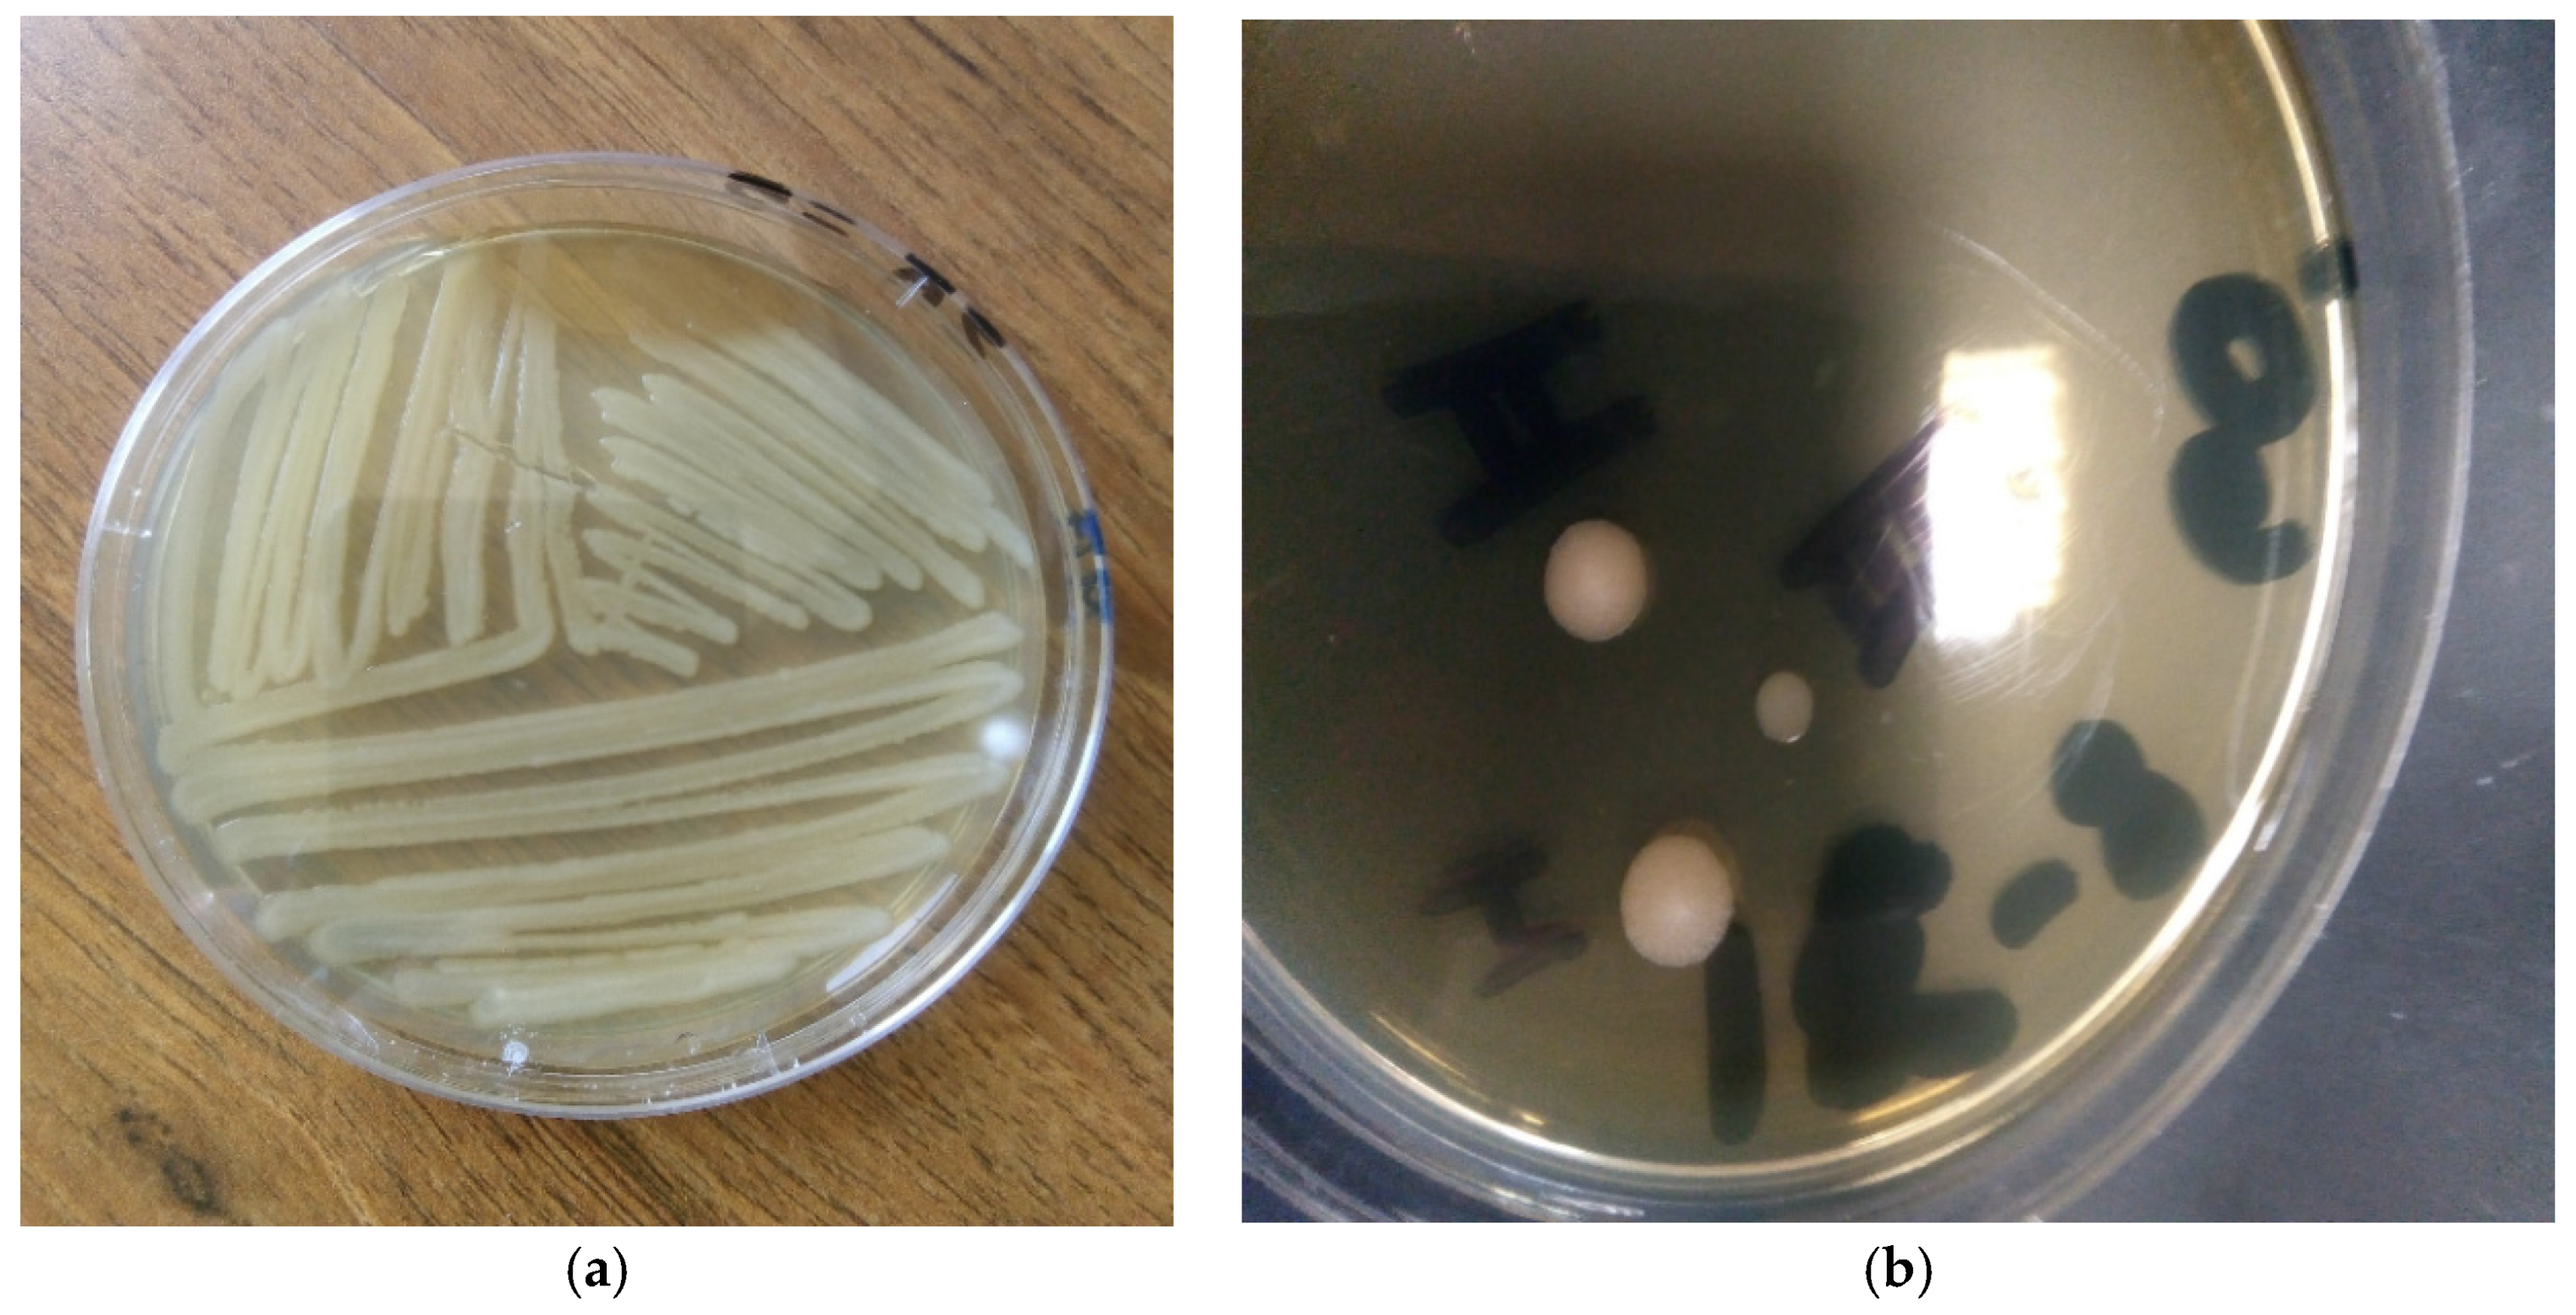
Proceedings 69 00005 g001

PHB Produced by Bacteria Present in the Argan Field Soil: A New Perspective for the Synthesis of the Bio-Based Polymer †
Abstract
:1. Introduction
2. Materials and Methods
2.1. Samples Collection
2.2. Pretreatment: Isolation of Microorganisms
2.3. Screening for PHB-Producing Bacteria
2.3.1. Schaeffer-Fulton Endospore Staining Using Malachite Green and Safranin
2.3.2. Schaeffer-Fulton Endospore Staining Using Methylene Blue Solutions
3. Results and Discussion
3.1. Isolation and Screening of PHB Producing Bacteria
3.2. Identification of PHB-Producing Bacteria by Schaeffer-Fulton Endospore Staining
4. Conclusions
Conflicts of Interest
Abbreviations
| PHB | polyhydroxybuthyrate |
| PHA | polyhydroxyalkanoates |
| 4-HB | 4-hydroxybutyrate |
| 3-HV | 3-hydroxyvalerate |
| 3-HH | 3-hydroxyhexanoate |
| PP | polypropylene |
| P3-HB-co-3HHx | Poly-3-hydroxybutyrate-co-3-hydroxyhexanoate |
| Tg | Glass transition temperature |
References
- Kabashi, S. Bio-Based Plastics: Material and Applications, 1st ed.; Wiley Series in Renewable Resources; Fraunhofer-Institute for Environmental, Safety, and Energy Technology UMSICHT: Oberhausen, Germany, 2014; pp. 1–5. [Google Scholar]
- Mallick, N.; Sharma, L.; Singh, A.K. Poly-b-hydroxybutyrate accumulation in Nostoc mus- corum: Effects of metabolic inhibitors. J. Plant Physiolog. 2007, 164, 312–317. [Google Scholar] [CrossRef]
- Koller, M.; Gasser, I.; Schmid, F.; Berg, G. Linking ecology with economy: insights into polyhydroxyalkanoate-producing microorganisms. Eng. Life Sci. 2011, 11, 222–237. [Google Scholar] [CrossRef]
- Stal, L.J. Poly(hydroxyalkanoate) in cyanobacteria: An overview. FEMS Microbiol. Rev. 1992, 103, 169–180. [Google Scholar] [CrossRef]
- Balaji, S.; Gopi, K.; Lavanya, B.; Muthuvelan, B. Isolation and optimization of poly-hydroxy- butyrate producing cyanobacterial strains. Int. J. Appl. Biol. Pharm. Technol. 2012, 3, 137–145. [Google Scholar]
- Lillo, J.A.G.; Rodriguez-Valera, F. Effects of culture conditions on poly (β-hydroxybutyric acid) production by Haloferax mediterranei. Appl. Environ. Microbiol. 1990, 56, 2517–2521. [Google Scholar] [CrossRef] [PubMed]
- Poli, A.; Di Donato, P.; Abbamondi, G.R.; Nicolaus, B. Synthesis, production, and biotechnological applications of exopolysaccharides and polyhydroxyalkanoates by archaea. Archaea 2011. [Google Scholar] [CrossRef] [PubMed]
- Braunegg, G.; Lefebvre, G.; Genser, K.F. Polyhydroxyalkanoates, biopolyesters from renewable resources: Physiological and engineering aspects. J. Biotechnol. 1998, 65, 127–161. [Google Scholar] [CrossRef]
- Van de Velde, K.; Kiekens, P. Biopolymers: Overview of several properties and consequences on their applications. Polym. Test. 2001, 21, 433–442. [Google Scholar] [CrossRef]
- Koller, M.; Salerno, A.; Braunegg, G. Polyhydroxyalkanoates: Basics, Production and Applications of Microbial Biopolyesters. In Bio-Based Plastics: Material and Applications, 1st ed.; Wiley Series in Renewable Resources; Fraunhofer-Institute for Environmental, Safety, and Energy Technology UMSICHT: Oberhausen, Germany, 2014; pp. 137–163. [Google Scholar]
- Tan, D.; Xue, Y.S.; Aibaidula, G.; Chen, G.Q. Unsterile and continuous production of poly- hydroxybutyrate by Halomonas TD01. Bioresour. Technol. 2011, 102, 8130–8136. [Google Scholar] [CrossRef] [PubMed]
- Angelini, S.; Cerruti, P.; Immirzi, B.; Poskovic, M.; Santagata, G.; Scarinzi, G.; Malinconico, M. From Microbial Biopolymers to Bioplastics: Sustainable Additives for PHB Processing and Stabilization. In Microbial Factories; Springer: New Delhi, India, 2015; pp. 139–160. [Google Scholar] [CrossRef]
- Rossini, G.; Toscano, G.; Duca, D.; Corinaldesi, F.; Foppa Pedretti, E.; Riva, G. Analysis of the characteris- tics of the tomato manufacturing residues finalized to the energy recovery. Biomass Bioenergy 2013, 51, 177–182. [Google Scholar] [CrossRef]
- Solaiman, D.K.Y.; Ashby, R.D.; Foglia, T.A.; Marmer, W.N. Conversion of agricultural feedstock and co-products into poly(hydroxyalkanoates). Appl. Microbiol. Biotechnol. 2006, 71, 783–789. [Google Scholar] [CrossRef] [PubMed]
- Khardenavis, A.A.; Kumar, M.S.; Mudliar, S.N.; Chakrabarti, T. Biotechnological conversion of agro-industrial wastewaters into biodegradable plastic, polyhydroxybutyrate. Bioresour. Technol. 2007, 98, 3579–3584. [Google Scholar] [CrossRef] [PubMed]
- Khanna, S.; Srivastava, A.K. Recent advances in microbial polyhydroxyalkanoates. Process. Biochem. 2005, 40, 607–619. [Google Scholar] [CrossRef]
- Thapa, C.; Shakya, P.; Shrestha, R.; Pal, S.; Manandhar, P. Isolation of Polyhydroxybutyrate (PHB) Producing Bacteria, Optimization of Culture Conditions for PHB production, Extraction and Characterization of PHB. Nepal J. Biotechnol. 2018, 6, 62–68. [Google Scholar] [CrossRef]
- Zayaitz, A.; Hussey, M.A. Endospore Staining Protocol. Am. Soc. Microbiol. 2007. Available online: https://www.asmscience.org/content/education/protocol/protocol.3112 (accessed on 3 October 2020).
- Oktari, A.; Supriatin, Y.; Kamal, M.; Syafrullah, H. The Bacterial Endospore Stain on Schaeffer Fulton using Variation of Methylene Blue Solution. J. Phys. IOP Conf. Ser. 2017, 812, 012066. [Google Scholar] [CrossRef]
- Mikkili, I.; Karlapudi, A.P.; Venkateswarulu, T.C.; Babu, D.J.; Nath, S.B.; Kodali, V.P. Isolation, screening and extraction of polyhydroxybutyrate (PHB) producing bacteria from sewage sample. Int. J. Pharm. Tech. Res. 2014, 6, 850–857. [Google Scholar]
- Kaliwal, B.B.; Biradar, G.G.; Shivasharana, C.T. Isolation and characterization of polyhydroxybutyrate (PHB) producing Bacillus species from agricultural soil. Eur. J. Exp. Biol. 2015, 5, 58–65. [Google Scholar]

Publisher’s Note: MDPI stays neutral with regard to jurisdictional claims in published maps and institutional affiliations. |
© 2020 by the authors. Licensee MDPI, Basel, Switzerland. This article is an open access article distributed under the terms and conditions of the Creative Commons Attribution (CC BY) license (https://creativecommons.org/licenses/by/4.0/).
Share and Cite
Aragosa, A.; Specchia, V.; Frigione, M. PHB Produced by Bacteria Present in the Argan Field Soil: A New Perspective for the Synthesis of the Bio-Based Polymer. Proceedings 2021, 69, 5. https://doi.org/10.3390/CGPM2020-07226
Aragosa A, Specchia V, Frigione M. PHB Produced by Bacteria Present in the Argan Field Soil: A New Perspective for the Synthesis of the Bio-Based Polymer. Proceedings. 2021; 69(1):5. https://doi.org/10.3390/CGPM2020-07226
Chicago/Turabian StyleAragosa, Amina, Valeria Specchia, and Mariaenrica Frigione. 2021. "PHB Produced by Bacteria Present in the Argan Field Soil: A New Perspective for the Synthesis of the Bio-Based Polymer" Proceedings 69, no. 1: 5. https://doi.org/10.3390/CGPM2020-07226
APA StyleAragosa, A., Specchia, V., & Frigione, M. (2021). PHB Produced by Bacteria Present in the Argan Field Soil: A New Perspective for the Synthesis of the Bio-Based Polymer. Proceedings, 69(1), 5. https://doi.org/10.3390/CGPM2020-07226

